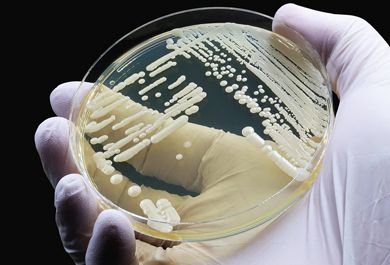
Der unkomplizierte Harnwegsinfekt – erfolgreiche Therapie und Prophylaxe

Clostridioides difficile-Infektionen (CDI) gehen mit einer hohen Mortalitätsrate von 20 % einher. Dies gilt vor allem für rezidivierende CDI. Die finanzielle Belastung für das Gesundheitswesen ist erheblich. Eine der Hauptursachen ist ein übermäßiger und unsachgerechter Antibiotikagebrauch, da er die Darmmikrobiota schädigt und somit die Anfälligkeit für eine Besiedlung und Infektion mit pathogenen C. difficile-Stämmen erhöht. Der Erreger wird fäkal-oral über seine ubiquitär vorkommenden Sporen übertragen. Die von der vegetativen Form produzierten Enterotoxine sind für die typischen gastrointestinalen Symptome verantwortlich. Eine zentrale Maßnahme zur Reduktion der CDI-Inzidenz sind der rationale Antibiotikaeinsatz und Antibiotic-Stewardship-(ABS-)Programme. Diese zielen vor allem auf die Einschränkung des Einsatzes von Fluorchinolonen, Cephalosporinen und Clindamycin ab. Bei Verdacht auf CDI ist eine frühzeitige zweistufige Erregerdiagnostik essenziell. Der Einsatz eines spezifischen Engspektrumantibiotikums ist entscheidend, um eine weitere Schädigung der Darmmikrobiota und damit das Risiko für künftige Rezidive zu reduzieren.
Unsere urologischen Fortbildungen bieten aktuelles, evidenzbasiertes Wissen aus der Urologie. Schwerpunkte sind Prostatakarzinom, benigne Prostatahyperplasie, Urolithiasis, Harninkontinenz, Harnwegsinfektionen sowie moderne Diagnostik, Bildgebung, operative und medikamentöse Therapien nach Leitlinie. Relevant für Klinik und Praxis, zertifiziert und kostenlos.





Infektionen und Harnsteine – von der Diagnostik zur richtigen Therapie
Harnsteine können sowohl Ursache als auch Folge von Harnwegsinfekten (HWI) sein. Der diagnostische und therapeutische Algorithmus ist jedoch unabhängig von der Entität weitgehend ähnlich. Einen hohen Stellenwert nimmt hierbei die Beseitigung der Obstruktion ein, da ein Harnaufstau eine Verschlechterung der Nierenfunktion und die Entstehung einer Urosepsis begünstigt. Kommt es dennoch zu einer Urosepsis, sind Procalcitonin (PCT) und Laktat wichtige Marker – sowohl für die Diagnostik als auch für das Therapiemonitoring. Therapeutisch sind darüber hinaus eine frühzeitige empirische Antibiotikatherapie und Flüssigkeitssubstitution indiziert. Aufgrund der zunehmend angespannten Resistenzlage müssen hierfür gegebenenfalls auch neuere Antibiotikakombinationen evaluiert werden.
Am Ende dieser Fortbildung kennen Sie...

Individualisierte Therapie des Prostatakarzinoms: Von Mikrobiom bis Tripeltherapie
Auf dem diesjährigen Uro Expert Summit wurden auch neue Daten zum Prostatakarzinom von der letzten ASCO-GU-Tagung vorgestellt und diskutiert. Neben erstmaligen Daten zum Zusammenhang zwischen Darmgesundheit und Prostata-spezifischer Antigen-(PSA-)Progression wurden neue Daten aus den ENZA-P-, TALAPRO-2- und AMPLITUDE-Studien bei Patienten mit einem metastasierten kastrationsresistenten Prostatakarzinom (mCRPC) präsentiert. Die EMBARK-Studie belegt bei Patienten mit einem in der konventionellen Bildgebung nicht metastasierten Prostatakarzinom, mit einem biochemischen Rezidiv (BCR) und mit hohem Progressionsrisiko die Wirksamkeit von Enzalutamid und Leuprorelin. Ein Schwerpunkt war die aktuelle Darstellung des Stellenwertes von Dual- und Tripeltherapie mit Darolutamid bei Patienten mit einem metastasierten hormonsensitiven Prostatakarzinom (mHSPC) basierend auf den Ergebnissen der ARANOTE- und ARASENS-Studien. Eine alleinige Androgendeprivation ist bei diesen Patienten zunehmend obsolet und hat in der aktuellen S3-Leitlinie keine Empfehlung mehr. Der PSA-Nadir etabliert sich durch neue Analysedaten als wichtiger prognoserelevanter Faktor beim mHSPC. Ein gutes Sicherheitsprofil der Kombinationspartner ist für die Dual- und Tripeltherapie relevant.
Am Ende dieser Fortbildung kennen Sie...

Highlights vom ASCO und ASCO-GU – Update Prostatakarzinom
Auf der letzten Jahrestagung der American Society of Clinical Oncology (ASCO) und dem ASCO-Genitourinary (GU) Cancers Symposium wurden wieder interessante Ergebnisse von zahlreichen kleineren Studien zum Prostatakarzinom präsentiert. Bei Patienten mit einem metastasierten kastrationsresistenten Prostatakarzinom (mCRPC) mit Mutationen der homologen Rekombinationsreparatur (HRR) wurden weitere Daten vorgestellt, die den Vorteil einer First-Line-Kombination aus Androgenrezeptor-Signalweg-(ARPI-)Inhibitor und Poly-(ADP-ribose-)Polymerasen-(PARP-)Inhibitor stützen. Zirkulierende Tumor-DNA (ctDNA) wurde auch beim mCRPC als relevanter Prognosemarker bestätigt. Nebenwirkungen einer Androgendeprivationstherapie (ADT) können mit einer kognitiven Verhaltenstherapie günstig beeinflusst werden. Bei Patienten mit einem metastasierten hormonsensiblen Prostatakarzinom (mHSPC) ist zur Therapiesteuerung auch eine regelmäßige Bildgebung wichtig. Wichtigstes Behandlungsziel beim mHSPC ist die Verlängerung der Zeit bis zur Kastrationsresistenz. Eine früh einsetzende Dreifachtherapie mit ARPI, Docetaxel und ADT erzielte bislang sehr gute Ergebnisse, was weitere Auswertungen der ARASENS-Studie eindrucksvoll belegen.
Am Ende dieser Fortbildung kennen Sie...

Neurogene Detrusorüberaktivität
Die neurogene Detrusorüberaktivität (englisch „neurogenic detrusor overactivity“, NDO) tritt häufig bei Querschnittlähmung nach Rückenmarksverletzung sowie bei neurologischen Systemerkrankungen wie der Multiplen Sklerose auf. NDO kann zu Harninkontinenz sowie zu urologischen Komplikationen wie beispielsweise zu einem vesikoureterorenalen Reflux aufgrund einer vesikalen Hochdrucksituation führen und kann die Lebensqualität erheblich mindern. Bei der Diagnostik und der Therapieplanung kommt es auf ein individuelles Konzept an, im Rahmen dessen verschiedene Optionen abgewogen werden müssen, um die bestmögliche Lebensqualität zu gewährleisten. Konservative Ansätze beinhalten die Gabe von Anticholinergika wie zum Beispiel Oxybutynin, Trospiumchlorid oder Propiverin, die die Detrusorüberaktivität hemmen. Diese werden häufig in bei Anurie in Kombination mit dem intermittierenden Einmalkatheterismus eingesetzt. Diese Medikamente weisen jedoch Nebenwirkungen wie Mundtrockenheit, Obstipation und kognitive Beeinträchtigungen auf. Als Alternative können Beta-3-Sympathomimetika wie Mirabegron oder seit Kurzem auch Vibegron (beides off Label) genutzt werden. Wenn orale medikamentöse Therapien nicht oder nicht ausreichend wirken, stellt die Injektion von Botulinumtoxin Typ A (BoNT-A) in die Detrusormuskulatur eine vielversprechende Therapieoption dar. BoNT-A zeigt eine hohe Wirksamkeit bei gleichzeitig guter Verträglichkeit. Bei Therapieversagen kann eine Dosiserhöhung oder ein BoNT-A-Präparatewechsel sinnvoll sein. Bei weiterhin unzureichender Wirksamkeit müssen unter Umständen operative Therapieoptionen diskutiert werden.
Am Ende dieser Fortbildung kennen Sie...

Pathophysiologie und Therapie von Harnwegsinfektionen
Durch das Bakterium Escherichia coli oder den Sprosspilz Candida albicans ausgelöste einfache Harnwegsinfektionen sind häufig und folgen einem Ablauf komplexer mikrobieller Besiedelungsprozesse im Harntrakt, die zu einer Immunantwort des Körpers führen. Die Behandlung mit Antibiotika oder Antimykotika richtet sich nach dem Erreger, dessen Resistenzstatus sowie nach bestehenden Komorbiditäten des Patienten. Bei E. coli kommen meist Antibiotika wie Fosfomycin, Nitrofurantoin, Nitroxolin oder Pivmecillinam zum Einsatz, bei symptomatischen Candida-Harnwegsinfektionen Antimykotika wie Fluconazol oder Nitroxolin. Die Zunahme antibiotikaresistenter E. coli-Stämme und rezidivierender Infektionen erfordert einen verantwortungsvolleren Einsatz von Antibiotika, eine exakte Diagnostik und die Entwicklung multimodaler alternativer Therapiestrategien. Zur Reduktion des Antibiotikaverbrauches kommen prophylaktische oder therapeutische Ansätze infrage. Diese basieren u. a. auf pflanzlichen oder synthetischen Wirkstoffen zur Hemmung der Bakterienadhäsion an das Urothel – aber auch auf Immunisierungsstrategien und Probiotika.
Am Ende dieser Fortbildung kennen Sie...

Harnwegsinfekte von unkompliziert bis rezidivierend
Harnwegsinfekte sind häufig, insbesondere bei Frauen und geriatrischen Patienten. Ärzte verschiedener Fachrichtungen werden regelmäßig damit konfrontiert. Aufgabe des Klinikers ist es einerseits, unnötige Diagnostik und Behandlungen zu vermeiden, und andererseits, einen bestehenden Diagnostik- und Therapiebedarf zügig zu identifizieren und anzugehen. Basierend auf der kürzlich aktualisierten Leitlinie der Deutschen Gesellschaft für Urologie wird im Folgenden der Umgang mit asymptomatischer Bakteriurie, unkomplizierten und rezidivierenden Infekten der unteren und oberen Harnwege, in diversen Risikogruppen erläutert. Ein besonderer Fokus liegt auf geriatrischen Patienten. Diverse Symptomenkomplexe und Verläufe werden durch Fallbeispiele veranschaulicht. Diese Fortbildung vermittelt praxisnahe Empfehlungen zur nicht pharmakologischen und pharmakologischen Behandlung akuter Harnwegsinfekte sowie zu geeigneten prophylaktischen Maßnahmen. Darüber hinaus werden Hilfsmittel aufgezeigt, die eine Risikoeinschätzung gängiger Medikamente ermöglichen, in Bezug auf unerwünschte Wirkungen am Harntrakt.
Am Ende dieser Fortbildung kennen Sie...

Idiopathische überaktive Blase (iOAB) – Update 2024
Bei der idiopathischen überaktiven Blase handelt es sich um einen weitverbreiteten Symptomenkomplex mit dem Kernsymptom imperativer Harndrang mit oder ohne Dranginkontinenz, begleitet zumeist von Pollakisurie und Nykturie. Die Erkrankung führt häufig zu einer deutlichen Einschränkung der Lebensqualität. Sie stellt zudem eine hohe gesundheitsökonomische Belastung dar. Bei geriatrischen Patienten ist die Harninkontinenz Teil eines geriatrischen Syndroms. Bei der Diagnostik geht es vor allem darum, andere Ursachen der Symptomatik auszuschließen. Die therapeutische Palette reicht von allgemeinen Maßnahmen der Lebensführung über ein Blasen- und Beckenbodentraining bis hin zu einer Pharmakotherapie und minimalinvasiven Verfahren wie der Injektion von Botulinumtoxin A und der Neuromodulation. Die prophylaktische Gabe von Antibiotika in Rahmen von minimalinvasiven Verfahren sollte den Prinzipien des Antibiotic Stewardship folgen. Chirurgische Eingriffe stellen eine Ultima ratio dar. Behandlungsziel ist die Reduktion des imperativen Harndranges sowie der begleitenden Symptome und damit einhergehend die Verbesserung der diesbezüglichen Lebensqualität.
Am Ende dieser Fortbildung kennen Sie...

Der unkomplizierte Harnwegsinfekt der Frau
Der unkomplizierte Harnwegsinfekt der Frau ist weitverbreitet. Etwa 9 % aller Mädchen und Frauen ab zwölf Jahren erleiden einmal im Jahr einen solchen Infekt. Gerade bei rezidivierenden Verläufen ist er häufig mit einem großen Leidensdruck der Betroffenen und zahlreichen antibiotischen Interventionen verbunden. Im Folgenden wird dargestellt, welche Harnwegsinfekte als unkompliziert zu betrachten sind, wie die diesbezüglichen Leitlinien zu interpretieren sind, wie diagnostiziert und wie im Akutfall, aber auch prophylaktisch behandelt werden kann. Dabei werden tiefere Einblicke in die Chancen und Limitationen der Diagnostik und der Behandlung unter besonderer Berücksichtigung der Pharmakologie, alternativer Strategien sowie klinisch praktischer Aspekte gegeben.
Am Ende dieser Fortbildung kennen Sie...

Männlicher Hypogonadismus
Der männliche Hypogonadismus ist ein klinisches Syndrom mit reduzierten Testosteronwerten im Serum und entsprechenden Symptomen. Mit zunehmendem Lebensalter nimmt seine Prävalenz aufgrund dann häufiger auftretender Komorbiditäten, die mit einem Hypogonadismus assoziiert sein können, zu. Die Symptome des männlichen Hypogonadismus werden bestimmt durch den Zeitpunkt seines Auftretens (pränatal, präpubertär, postpubertär) und durch das Ausmaß des Testosterondefizits. In Abhängigkeit von der anatomischen Lokalisation der Schädigung werden ein primärer (Schädigung der Hoden) und ein sekundärer (Störung von Hypothalamus/Hypophyse) Hypogonadismus unterschieden. Der funktionelle Hypogonadismus ist eine Mischform. Beispiel dafür ist der Altershypogonadismus („late-onset“ Hypogonadismus“, LOH). Darüber hinaus treten Symptome eines Hypogonadismus auch bei einer herabgesetzten Empfindlichkeit des Androgenrezeptors (AR) auf (Androgeninsensitivität). Die verschiedenen Formen des Hypogonadismus können zudem angeboren oder erworben sein. Am häufigsten tritt der funktionelle Hypogonadismus auf. Unter Berücksichtigung der Kontraindikationen kann die Therapie des Hypogonadismus durch verschiedene Formen der Testosterontherapie erfolgen. Hierdurch kommt es zur Besserung entsprechender Symptome und auch assoziierter Erkrankungen. Bei aktuellem Kinderwunsch ist eine Substitution mit Testosteron in der Regel kontraindiziert. Im Fall eines sekundären Hypogonadismus müssen dann Stimulationen mit HCG und rFSH erfolgen.
Am Ende dieser Fortbildung kennen Sie...
Der unkomplizierte Harnwegsinfekt – erfolgreiche Therapie und Prophylaxe
Der unkomplizierte Harnwegsinfekt (HWI) ist in der Primärversorgung häufig anzutreffen. Der wichtigste Erreger ist Escherichia coli. Nicht antibiotische Behandlungsstrategien gewinnen immer mehr an Bedeutung. Dennoch bleibt die Antibiotikatherapie für viele Patienten die Behandlung der Wahl. Um die Wirksamkeit sicherzustellen, ist eine Kenntnis der aktuellen lokalen Antibiotikaresistenzlage unerlässlich. In Deutschland gelten aktuell Fosfomycin-Trometamol, Nitrofurantoin, Nitroxolin und Pivmecillinam als Antibiotika der ersten Wahl. Bevor bei rezidivierenden HWI eine prophylaktische Antibiotikagabe begonnen wird, sollten die Risikofaktoren für die Entstehung von Rezidiven berücksichtigt werden und nicht antibiotische Strategien ausgeschöpft sein. Bei vielen Patienten ist eine Candidurie nachweisbar. Der Nachweis von Candida im Urin stellt allerdings allein und ohne vorliegende Symptomatik keine Behandlungsindikation dar. Bei Patienten mit Harnkatheter und Candidurie reicht in vielen Fällen die Entfernung oder der Wechsel des Katheters zur Sanierung aus. Zur antimykotischen Therapie von gesicherten HWI mit Candida-Spezies steht eine Reihe wirksamer Antimykotika zur Verfügung.





